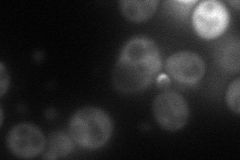
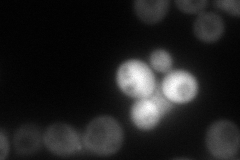
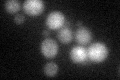

View description
LIM domain-containing protein that localizes to sites of polarized growth, required for selection and/or maintenance of polarized growth sites, may modulate signaling by the GTPases Cdc42p and Rho1p; has similarity to metazoan paxillin
Localization:
Intensity:
Fold change:
Significance:
-
C’ GFP library in SD

below threshold19.61 -
N' NOP1pr-GFP in SD
bud51.651 -
N' TEF2pr-mCherry in SD
bud71.6528 -
N' NATIVEpr-GFP in SD

bud neck29.1018 -
N' TEF2pr-VC and Cyto-VN in SD

bud43.3039 -
C’ GFP library in SD+DTT
cytosol17.630.89No -
C’ GFP library in SD+H2O2

cytosol19.10.97No -
C’ GFP library in Starvation Media

cytosol14.640.74No -
C’ GFP library on the background of Pup2-DaMP

below threshold -
C’ GFP library on the background of CCT mutant

below threshold19.95421.01724No
